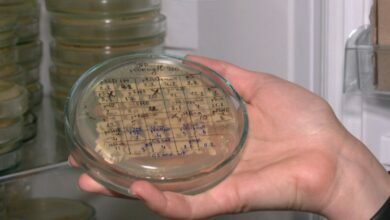
разработка вакцины

вакцина
-
Общество
%22%20transform%3D%22translate(.8%20.8)%20scale(1.52344)%22%20fill-opacity%3D%22.5%22%3E%3Cellipse%20fill%3D%22%23dce0dc%22%20rx%3D%221%22%20ry%3D%221%22%20transform%3D%22matrix(-6.9536%20-96.65872%2029.97103%20-2.15611%20253.4%2072)%22%2F%3E%3Cellipse%20fill%3D%22%2367667e%22%20rx%3D%221%22%20ry%3D%221%22%20transform%3D%22matrix(-26.334%20-139.6989%2036.44135%20-6.8694%203.4%2044.6)%22%2F%3E%3Cellipse%20fill%3D%22%235b5f5b%22%20cx%3D%22183%22%20cy%3D%2210%22%20rx%3D%2227%22%20ry%3D%2227%22%2F%3E%3Cellipse%20fill%3D%22%23ea6e95%22%20rx%3D%221%22%20ry%3D%221%22%20transform%3D%22matrix(19.48212%20-40.12185%2032.70002%2015.87828%20188.5%20139)%22%2F%3E%3C%2Fg%3E%3C%2Fsvg%3E)
В Украине «ковидную» тысячу будут выплачивать и несовершеннолетним
Украинские граждане в возрасте 12-18 лет тоже будут получать 1000 гривен за вакцинацию
-
Общество
%27%20fill-opacity%3D%27.5%27%3E%3Cellipse%20fill%3D%22%2300122d%22%20fill-opacity%3D%22.5%22%20rx%3D%221%22%20ry%3D%221%22%20transform%3D%22matrix(-14.56896%20-99.92526%2068.4079%20-9.97378%20200.3%20186.8)%22%2F%3E%3Cellipse%20fill%3D%22%23aab8b2%22%20fill-opacity%3D%22.5%22%20rx%3D%221%22%20ry%3D%221%22%20transform%3D%22rotate(-9.4%20706.3%20-466.8)%20scale(60.8332%2087.22443)%22%2F%3E%3Cellipse%20fill%3D%22%23d59600%22%20fill-opacity%3D%22.5%22%20rx%3D%221%22%20ry%3D%221%22%20transform%3D%22rotate(64%20126.4%20265.9)%20scale(388.47669%2081.24832)%22%2F%3E%3Cpath%20fill%3D%22%23efb336%22%20fill-opacity%3D%22.5%22%20d%3D%22M99.8%20235.4l-123.4-16.8L9.9%203.8z%22%2F%3E%3C%2Fg%3E%3C%2Fsvg%3E)
Украина сократит срок действия COVID-сертификатов о вакцинации до 270 дней
Сейчас этот сертификат действует в течение одного года
-
Общество
%27%20fill-opacity%3D%27.5%27%3E%3Cellipse%20fill%3D%22%23121213%22%20fill-opacity%3D%22.5%22%20rx%3D%221%22%20ry%3D%221%22%20transform%3D%22matrix(-93.56197%208.95729%20-5.69816%20-59.51929%2016.3%20.8)%22%2F%3E%3Cellipse%20fill%3D%22%23e1e1e3%22%20fill-opacity%3D%22.5%22%20rx%3D%221%22%20ry%3D%221%22%20transform%3D%22matrix(10.40216%2072.94829%20-26.4822%203.77627%20253.3%2024.4)%22%2F%3E%3Cellipse%20fill%3D%22%236a7244%22%20fill-opacity%3D%22.5%22%20rx%3D%221%22%20ry%3D%221%22%20transform%3D%22matrix(-34.17728%2076.89016%20-52.83961%20-23.48694%20359.8%20201.1)%22%2F%3E%3Cellipse%20fill%3D%22%23adadaf%22%20fill-opacity%3D%22.5%22%20rx%3D%221%22%20ry%3D%221%22%20transform%3D%22matrix(344.33448%20-133.4484%2020.8224%2053.72765%20170.9%2094.1)%22%2F%3E%3C%2Fg%3E%3C%2Fsvg%3E)
Украина вводит бустерную вакцинацию от COVID для всех граждан старше 18 лет
Для бустерной дозы предпочтение будут отдавать м-РНК-вакцинам - Moderna или Pfizer, независимо от того, какой вакциной ранее был привит человек.
-
Общество
%22%20transform%3D%22translate(.8%20.8)%20scale(1.52344)%22%20fill-opacity%3D%22.5%22%3E%3Cellipse%20fill%3D%22%23d8d8d8%22%20rx%3D%221%22%20ry%3D%221%22%20transform%3D%22matrix(58.16755%20-16.7892%2023.60617%2081.78549%20231.8%2062.5)%22%2F%3E%3Cellipse%20fill%3D%22%233b3b3b%22%20rx%3D%221%22%20ry%3D%221%22%20transform%3D%22rotate(-99.2%2099.8%20-1)%20scale(214.02494%2034.25426)%22%2F%3E%3Cpath%20fill%3D%22%23383838%22%20d%3D%22M76.8-15.7L3.4%20166l-60.2-24.3L16.6-40z%22%2F%3E%3Cellipse%20fill%3D%22%23dadada%22%20cx%3D%22245%22%20cy%3D%2228%22%20rx%3D%2225%22%20ry%3D%2282%22%2F%3E%3C%2Fg%3E%3C%2Fsvg%3E)
В Украине разрешили бустерную дозу вакцины от коронавируса для людей старше 60 лет
Для бустерной дозы предпочтение отдается м-РНК-вакцинам – Moderna или Comirnaty/Pfizer
-
Общество
%27%20fill-opacity%3D%27.5%27%3E%3Cellipse%20fill%3D%22%23004f93%22%20fill-opacity%3D%22.5%22%20rx%3D%221%22%20ry%3D%221%22%20transform%3D%22matrix(-131.45535%2037.6427%20-16.05902%20-56.08112%20349.9%20175.9)%22%2F%3E%3Cellipse%20fill%3D%22%23ffead6%22%20fill-opacity%3D%22.5%22%20rx%3D%221%22%20ry%3D%221%22%20transform%3D%22rotate(30.2%20-70.7%20147.8)%20scale(102.93079%20388.47668)%22%2F%3E%3Cellipse%20fill%3D%22%235aa9d8%22%20fill-opacity%3D%22.5%22%20rx%3D%221%22%20ry%3D%221%22%20transform%3D%22matrix(143.53518%20-124.27234%2048.90386%2056.4842%20298.7%2088)%22%2F%3E%3Cellipse%20fill%3D%22%23134d7a%22%20fill-opacity%3D%22.5%22%20rx%3D%221%22%20ry%3D%221%22%20transform%3D%22rotate(-126.5%20231.7%206.5)%20scale(43.23089%2069.02703)%22%2F%3E%3C%2Fg%3E%3C%2Fsvg%3E)
Японские учёные заявили, что разработали "пожизненную вакцину" от коронавируса
Вакцина с пожизненной эффективностью приведет к огромной финансовой экономии и позволит быстрее преодолеть пандемию
-
Общество
%22%20transform%3D%22translate(.8%20.8)%20scale(1.52344)%22%20fill-opacity%3D%22.5%22%3E%3Cellipse%20fill%3D%22%231c322d%22%20cx%3D%2238%22%20cy%3D%2268%22%20rx%3D%2245%22%20ry%3D%22255%22%2F%3E%3Cellipse%20fill%3D%22%23d3b7c2%22%20rx%3D%221%22%20ry%3D%221%22%20transform%3D%22rotate(81%20106.2%20124.7)%20scale(126.44543%2089.13702)%22%2F%3E%3Cellipse%20fill%3D%22%23d86c84%22%20rx%3D%221%22%20ry%3D%221%22%20transform%3D%22matrix(-21.70282%2056.24417%20-75.83772%20-29.26334%20177.2%20123)%22%2F%3E%3Cellipse%20fill%3D%22%236b6e6e%22%20rx%3D%221%22%20ry%3D%221%22%20transform%3D%22matrix(4.12379%20-106.30346%2030.87608%201.19776%2065.2%2085.8)%22%2F%3E%3C%2Fg%3E%3C%2Fsvg%3E)
Разработку украинской COVID-вакцины больше не ведут из-за нехватки денег и отсутствия интереса у власти
Разработка отечественной вакцины против коронавируса, которую создали львовские ученые, приостановлена из-за отсутствия финансирования и заинтересованности со стороны властей
-
Общество
%22%20transform%3D%22translate(.8%20.8)%20scale(1.52344)%22%20fill-opacity%3D%22.5%22%3E%3Cellipse%20fill%3D%22%23e4eef6%22%20cx%3D%22255%22%20cy%3D%2276%22%20rx%3D%2295%22%20ry%3D%2251%22%2F%3E%3Cellipse%20fill%3D%22%23d97c33%22%20rx%3D%221%22%20ry%3D%221%22%20transform%3D%22rotate(41.3%2068.8%20238.5)%20scale(32.24184%2073.26186)%22%2F%3E%3Cellipse%20fill%3D%22%23685c65%22%20rx%3D%221%22%20ry%3D%221%22%20transform%3D%22rotate(-51.2%2014.7%20-15.2)%20scale(44.27067%2072.7064)%22%2F%3E%3Cellipse%20fill%3D%22%2355686e%22%20rx%3D%221%22%20ry%3D%221%22%20transform%3D%22matrix(-44.13166%201.3098%20-.70535%20-23.76584%20133.4%20136.8)%22%2F%3E%3C%2Fg%3E%3C%2Fsvg%3E)
Украинским медработникам начали колоть бустерную дозу вакцины
В пятницу, 24 декабря, в Украине началась ревакцинация от коронавируса медработников и сотрудников интернатов.
-
Общество
%22%20transform%3D%22translate(.6%20.6)%20scale(1.17188)%22%20fill-opacity%3D%22.5%22%3E%3Cellipse%20fill%3D%22%23c4cfd2%22%20cx%3D%22182%22%20cy%3D%2235%22%20rx%3D%2247%22%20ry%3D%2247%22%2F%3E%3Cellipse%20fill%3D%22%23421f1c%22%20rx%3D%221%22%20ry%3D%221%22%20transform%3D%22rotate(-92.8%20101.7%2038.6)%20scale(44.28296%20255)%22%2F%3E%3Cellipse%20fill%3D%22%23661205%22%20rx%3D%221%22%20ry%3D%221%22%20transform%3D%22matrix(23.55769%20-7.26435%2048.4507%20157.1216%200%2096.3)%22%2F%3E%3Cellipse%20fill%3D%22%23923000%22%20rx%3D%221%22%20ry%3D%221%22%20transform%3D%22matrix(6.00843%2049.59717%20-25.6978%203.11315%20255%20117)%22%2F%3E%3C%2Fg%3E%3C%2Fsvg%3E)
На что украинцы чаще всего тратят тысячу за вакцинацию
Министр культуры Александр Ткаченко обнародовал первые статистические данные по использованию "вакцинальной тысячи".
-
Общество
%22%20transform%3D%22translate(.8%20.8)%20scale(1.52344)%22%20fill-opacity%3D%22.5%22%3E%3Cellipse%20fill%3D%22%23fff%22%20rx%3D%221%22%20ry%3D%221%22%20transform%3D%22matrix(.6815%20-75.7818%2040.03028%20.36%200%2035.2)%22%2F%3E%3Cellipse%20fill%3D%22%238f8c8b%22%20cx%3D%2293%22%20cy%3D%22143%22%20rx%3D%2270%22%20ry%3D%2276%22%2F%3E%3Cellipse%20fill%3D%22%2344b6df%22%20rx%3D%221%22%20ry%3D%221%22%20transform%3D%22matrix(37.82347%20-6.44247%204.06645%2023.87396%20115.1%200)%22%2F%3E%3Cellipse%20fill%3D%22%23cecbca%22%20rx%3D%221%22%20ry%3D%221%22%20transform%3D%22rotate(90.2%2064.9%20141)%20scale(30.30462%2079.56699)%22%2F%3E%3C%2Fg%3E%3C%2Fsvg%3E)
Вакцинированные украинцы старше 60 лет смогут купить лекарства за «тысячу Зеленского» с января 2022 года
Украинцы, которые не имеют приложения "Дия", цифровых приложений банков или банковских карт, смогут получить деньги со второго квартала или со второго полугодия…